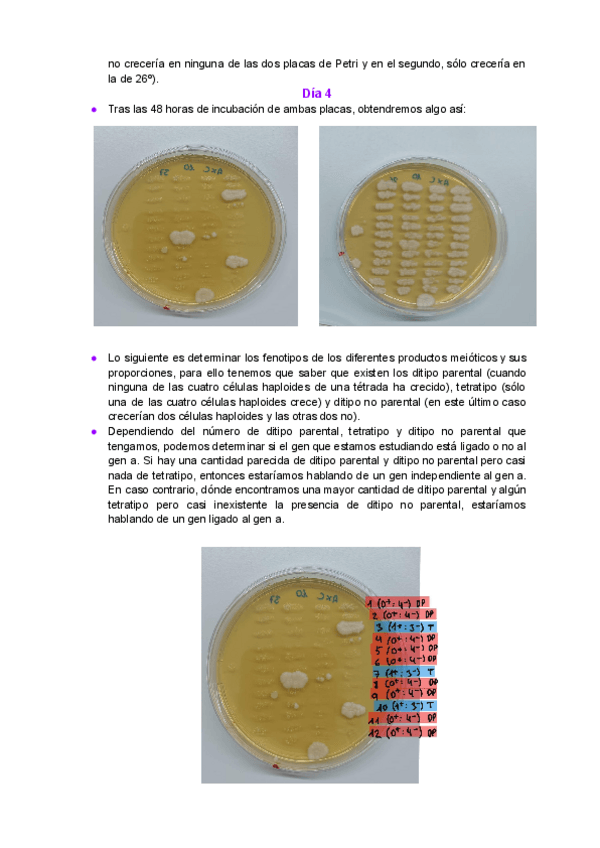
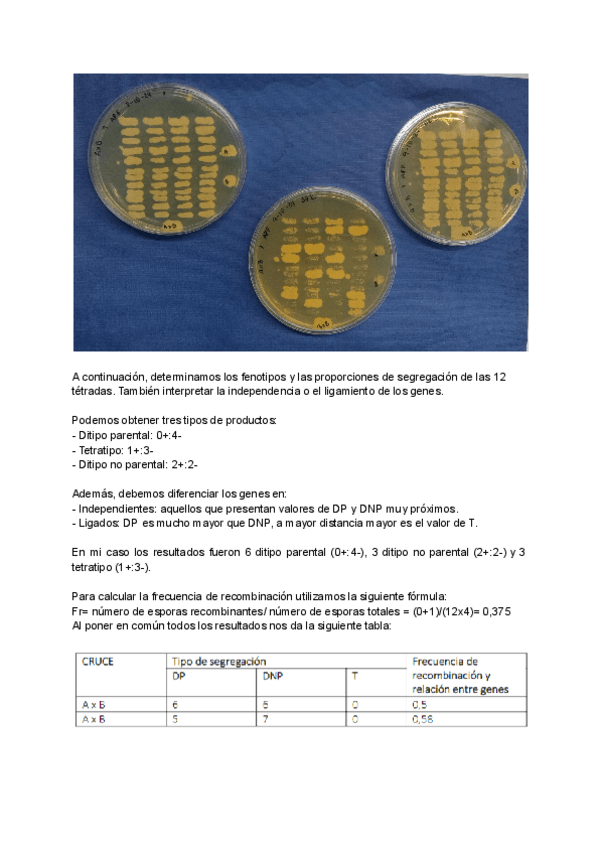

Genética I
ejercicios
-
Series mendeliana corregidas.
Todas las series del bloque de mendeliana corregidas con los enunciados. Curso 2025-2026.
Adjunto ejercicios resueltos de genética de la parte I, de mendeliana. Son las actividades que aparecen en las presentaciones de cada tema. Los temas que no tienen actividades es porque son teóricos.
He publicado nuevos examenes de 2º Genética I: examen-genetica-diciembre-2025.pdf
Minievaluación bloque de genética de poblaciones corregida con justificación de cada una.
He publicado nuevos ejercicios de 2º Genética I: problemas-extra-poblaciones-2024.pdf
He publicado nuevos apuntes de 2º Genética I: temas-poblaciones-2024.pdf
He publicado nuevos apuntes de 2º Genética I: Serie-4-genetica-25-26.pdf
He publicado nuevos apuntes de 2º Genética I: Serie-3-genetica-2025.pdf
He publicado nuevos apuntes de 2º Genética I: Serie-II-genetica-2025.pdf
apuntes
-
Teoría Genética
He publicado nuevos apuntes de 2º Genética I: Teoría Genética
Apuntes tema 6 de genética, herencia y sexo con imágenes explicativas
apuntes
-
Genética I
He publicado nuevos apuntes de 2º Genética I: Genética I
Adjunto apuntes del tema 5 (análisis genético en hongos) de genética I con dibujos explicativos.
Adjunto resumen del tema 4 de genética I con fotos explicativas.
apuntes
-
Genética I
Apuntes de genética del Bloque I: Tema 1. Base cromosómica y molecular de la herencia, Tema 2. Mitosis, meiosis y ciclos de vida en eucariontes, Tema 3. Análisis genético en eucariotas superiores, Tema 4. Ligamiento y recombinación y Tema 5. Análisis gené
Adjunto apuntes del tema tres de genética con fotos y dibujos explicativos.
He publicado nuevos ejercicios de 2º Genética I: SERIE-2-BLOQUE-2-GENETICA-I.pdf
He publicado nuevos practicas de 2º Genética I: practica-informatica-genetica-I.pdf
He publicado nuevos practicas de 2º Genética I: Informe-Laboratorio-Genetica-I.pdf
He publicado nuevos ejercicios de 2º Genética I: Serie-4-bloque-II-2024.pdf
He publicado nuevos ejercicios de 2º Genética I: Serie-3-bloque-II-2024.pdf
He publicado nuevos ejercicios de 2º Genética I: Serie-2-bloque-II-2024.pdf
He publicado nuevos ejercicios de 2º Genética I: Serie-1-bloque-II-2024.pdf
@Anónimo
Exámen Parcial - BLOQUE I_ Genética de Poblaciones - Genética I - 2024_2025
He publicado nuevos ejercicios de 2º Genética I: Serie-4-bloque-II.pdf
He publicado nuevos ejercicios de 2º Genética I: Serie-3-bloque-II.pdf
He publicado nuevos ejercicios de 2º Genética I: Serie-2-bloque-II.pdf
He publicado nuevos ejercicios de 2º Genética I: Serie-1-bloque-II.pdf
Están todas las formulas necesarias del bloque I y también hay un poco de teoría
He publicado nuevos ejercicios de 2º Genética I: SERIE-4-bloque-2-CORREGIDA.pdf
He publicado nuevos ejercicios de 2º Genética I: SERIE-3- bloque 2 GENETICA-I.pdf
He publicado nuevos apuntes de 2º Genética I: TEMA-1-GENETICA-BLOQUE-II.pdf
He publicado nuevos practicas de 2º Genética I: Informe-de-practicas-Genetica-I.pdf
ejercicios
-
PROBLEMAS BLOQUE II
He publicado nuevos ejercicios de 2º Genética I: PROBLEMAS BLOQUE II
He publicado nuevos apuntes de 2º Genética I: T8-ALTERACIONES-CROMOSOMICAS-bloque-2.pdf
He publicado nuevos apuntes de 2º Genética I: TEMAS-1-2-Y-3-BLOQUE-II.pdf
He publicado nuevos apuntes de 2º Genética I: T7-HERENCIA-EXTRANUCLEAR bloque 2.pdf
He publicado nuevos apuntes de 2º Genética I: T6-HERENCIA-Y-SEXO bloque 2.pdf
ejercicios
-
SERIES BLOQUE II
He publicado nuevos ejercicios de 2º Genética I: SERIES BLOQUE II
He publicado nuevos apuntes de 2º Genética I: TEMA-1-GENETICA B 2.pdf
He publicado nuevos apuntes de 2º Genética I: T5-ANALISIS-GENETICO-DE-HONGOS bloque 2.pdf
He publicado nuevos apuntes de 2º Genética I: T4-HERENCIA-DE-GENES-LIGADOS bloque 2.pdf
apuntes
-
Resúmenes Genética (2º parte)
He publicado nuevos apuntes de 2º Genética I: Resúmenes Genética (2º parte)